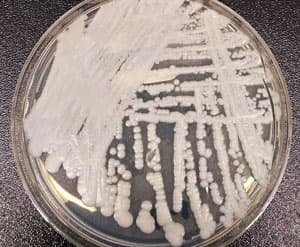
O’limga olib keladigan qo’ziqorin: o’sib borayotgan global salomatlik tahdidi – iqlim o’zgarishi aybdormi?  – Healthcare Asia Daily News |  Sog’liqni saqlash va tibbiyot sanoati, tibbiyot texnologiyalari, sog’liqni saqlash biznesi va ilmiy-tadqiqot ishlari, sog’liqni saqlash tadbirlari bo’yicha Osiyoning yetakchi yangiliklari va axborot manbai.  2010 yildan beri onlayn: Healthcare Asia Daily News

2023 yil 24 mart

Candida auris (C. auris) — 2009 yilda aniqlangan, bugungi kunda global tibbiyot tizimi uchun jiddiy xavf tug'dirayotgan, dorilarga chidamli zamburug' turi.
Nima uchun Candida auris xavfli?
CDC ma'lumotlariga ko'ra, ushbu patogen uchta asosiy sababga ko'ra xavotir uyg'otadi:
- Antifungal qarshilik: Ko'plab shtammlar zamonaviy antifungal dorilarga mutlaqo chidamli.
- Aniqlash qiyinligi: Standart laboratoriya usullari bilan uni aniqlash mushkul, bu esa noto'g'ri tashxis va samarasiz davolashga olib keladi.
- Kasalxona ichidagi yuqumlilik: Tibbiyot muassasalarida tez tarqalib, o'lim holatlarini keltirib chiqaradi.
2022 yil davomida 2 377 ta klinik va 5 754 ta skrining holati qayd etilgani vaziyatning jiddiyligini ko'rsatadi.
Iqlim o'zgarishi va qo'ziqorin tarqalishi
mBio jurnalida chop etilgan tadqiqotga ko'ra, iqlim o'zgarishi ushbu zamburug'ning moslashuvchanligiga ta'sir qilgan bo'lishi mumkin. C. auris 42°C gacha bo'lgan haroratga bardosh bera oladi, bu esa uni global isish sharoitida yanada chidamli qiladi.
JSSTning xavotiri
2022 yil oktyabr oyida JSST (WHO) o'zining birinchi "ustuvor patogenlar" ro'yxatini e'lon qildi. Unda global isish, xalqaro savdo va sayohatlar natijasida zamburug'li infeksiyalarning geografik qamrovi kengayib borayotgani ta'kidlangan.

Responses (0 )